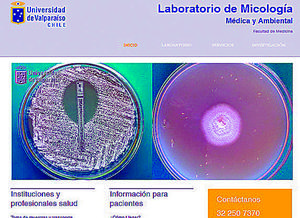

Más leídas

Chile | Pág. 19
Un lugar con identidad local abierto a todos los visitantes y comunidad de la región

Chile | Pág. 20
CIB-UV

Chile | Pág. 20
Enfermedades por alimentos: ¡cuidado con lo que comes!

Chile | Pág. 20
Laboratorios UV

Vida Social | Pág. 37
PUCV gradúa a nueva generación de los magíster en Relaciones Internacionales y en Dirección Pública

Vida Social | Pág. 39
Familias recibieron certificados como beneficiarios de Pavimentación Participativa

Espectáculos | Pág. 42
Usuarios relatan su experiencia en la Bibliometro de Valparaíso